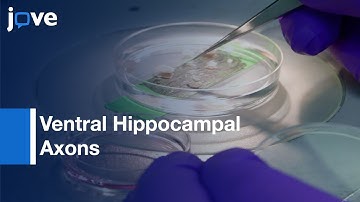
Calcium Signaling by Nicotine and Neurotransmitter Release in VH Axons | Protocol Preview

⬇ DOWNLOAD NOW
Kalau muncul iklan pop-up, tutup lalu klik tombol kembali
Download lagu Simultaneous Recording:Calcium Signals From Identified Neurons & Feeding Behavior l Protocol Preview secara gratis hanya untuk keperluan promosi. Dukung artis favorit kamu dengan membeli musik original di iTunes atau platform resmi lainnya.
 Simultaneous Multi-Region Neuronal Calcium Imaging in Freely Behaving Subjects
Simultaneous Multi-Region Neuronal Calcium Imaging in Freely Behaving Subjects
 Simultaneous recordings of intracellular calcium in astrocytes and extracellular ATP
Simultaneous recordings of intracellular calcium in astrocytes and extracellular ATP
 Calcium Signaling in Neuronal Motility: Supplemental Video
Calcium Signaling in Neuronal Motility: Supplemental Video
 Calcium Imaging Of Cortical Neurons Using Fura-2 AM l Protocol Preview
Calcium Imaging Of Cortical Neurons Using Fura-2 AM l Protocol Preview
Calcium Signaling by Nicotine and Neurotransmitter Release in VH Axons | Protocol Preview
Calcium Signaling by Nicotine and Neurotransmitter Release in VH Axons | Protocol Preview
 Functional Calcium Imaging In Developing Cortical Networks l Protocol Preview
Functional Calcium Imaging In Developing Cortical Networks l Protocol Preview
 Calcium Signaling
Calcium Signaling
 Calcium imaging in cerebellar neurons
Calcium imaging in cerebellar neurons